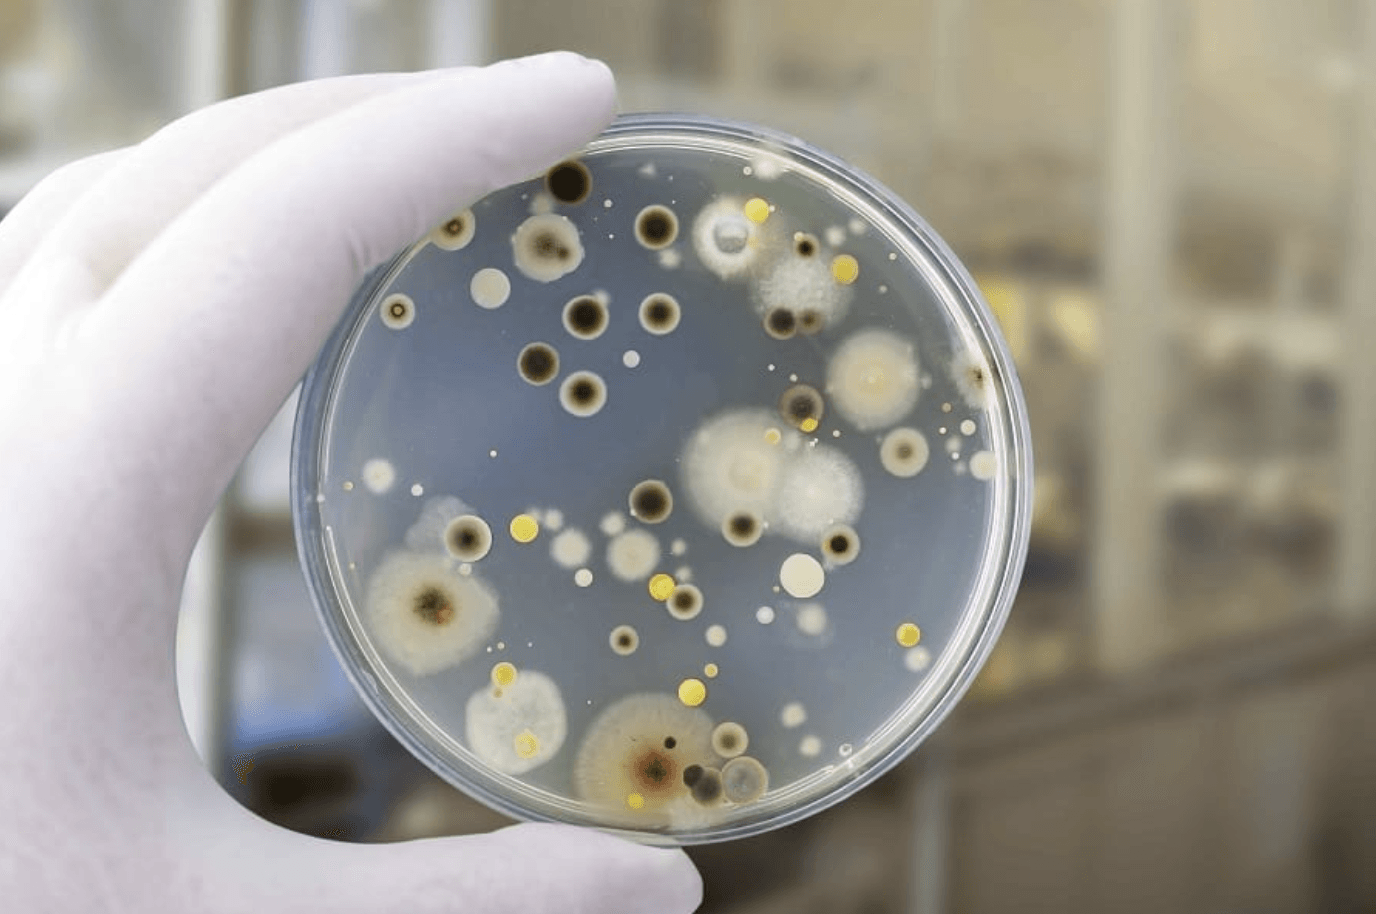

Believe it or not, mold is ubiquitous, meaning they can be found both outside and indoors. Some mold spores will be found floating in the air and in settled dust; however, they will not grow if moisture is not present.
When moisture is present, like a water loss or high humidity areas, it is important to work with
360 Restoration technicians who are water and mold certified that know how to properly evaluate, contain, and remediate the affected areas. If a non-certified company is doing the water damage restoration and is not mold remediation certified, there is a risk of the mishandling of the mold or having to stop the project to bring in a mold certified company.
Call us at 513-499-0166 or email us at 360restorationllc@gmail.com.


The top 3 signs you may have mold growth
- A musty smell- Mold has a distinct smell, often characterized as a musty or earthy smell. Although you may smell this odor there is a chance you may not be able to see the growth. To help locate the areas that are affected, look for areas that may have been exposed to water such as below a leaking pipe, leaking foundation wall, or even water damage you have not discovered yet.
- Material discoloration- Microbial growth can be black, dark green, dark brown, and even in some cases red or pink. Most microbial growth appears fuzzy and may appear as long areas along your ceiling, floor, or walls.
- Water damage spots- Did you happen to have a roof leak, pipe burst, sump pump overflow, or another water loss? Microbial growth can set in as soon as 24-48 hours of a water exposure. With the quick timeline, it is important to hire an experienced water damage restoration company but more importantly a mold certified company in the event of microbial growth.
360 Restoration takes the health and safety of our clients, employees, and general population very seriously when handling mold. We will work diligently with you, your property manager, indoor hygienist, or insurance representative to come up with the most appropriate course of action for the building but most importantly the occupants!
Apartment with Mold
What we did-
An unhappy tenant decided to clog the bathroom tub and flooded this entire apartment. The issue was discovered more than a couple weeks later with the water still on! We were tasked with testing, evaluating, and remediating the mold from this apartment. Quite a large amount of demolition was needed due to the mold growing within the walls. Our certified technicians remediated every square inch of the property after demolition and then sealed it with an antimicrobial sealer. The property is now safe and prepared for reconstruction!

Click these links to view immersive documentation
After Remediation- Apartment Building- Mold damage (matterport.com)